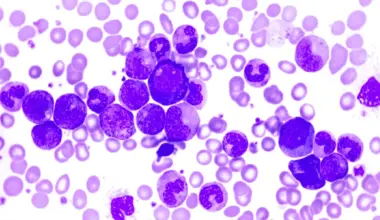

El sarro es un problema dental con síntomas muy dañinos. Descubre cómo prevenirlo y eliminarlo.
Incluso si cuidamos nuestros dientes y mantenemos una buena higiene dental en casa, las bacterias presentes en nuestra boca todavía permanecen en ella. Cuando estas bacterias se mezclan con restos de alimentos puede formarse una película en los dientes llamada placa dental.
Si bien la placa dental es fácil de prevenir y eliminar con el cepillado diario, si este no se lleva a cabo puede aparecer una condición más grave llamada sarro. A lo largo de este artículo descubriremos qué es el sarro, sus causas y cómo eliminarlo y prevenir su aparición.
¿Qué es el sarro dental?
El sarro, también conocido como cálculo dental, es una afección bucal en la que se produce la formación de una placa dental endurecida. Esta barrera, de mayor consistencia que la placa dental habitual, es causada por una acumulación de minerales de la saliva y del fluido crevicular gingival en la placa de los dientes.
Este proceso de acumulación mata las células bacterianas que se encuentran dentro de la placa dental. Sin embargo, la superficie dura y rugosa que se forma proporciona la base perfecta para la formación de más placa adicional. Esto provoca la acumulación de sarro, el cual puede resultar muy dañino para la salud de las encías.
El sarro puede formarse a lo largo de toda la línea de la encía, lo que se conoce como sarro supragingival, y también el pequeño surco que existe entre los dientes y la encía; en este caso hablamos de sarro subgingival.
La formación de sarro en los dientes suele estar asociada con una amplia variedad de condiciones clínicas entre las que se incluyen el mal aliento, el retraimiento y la inflamación crónica de las encías.
El cepillado diario y la utilización de complementos de limpieza, como el hilo dental, puede eliminar la placa previa a la formación del sarro. No obstante, una vez este se ha formado es demasiado duro como para ser eliminado con el cepillado.
Por lo tanto, para poder quitar el sarro de los dientes se debe recurrir a la intervención profesional. Entre los procedimientos odontológicos para eliminar el sarro destaca la utilización de herramientas ultrasónicas o de instrumentos manuales dentales, como los raspadores periodontales.
¿Cómo se forma? Causas
Al comer la saliva, los alimentos y los fluidos se mezclan en la boca creando un medio ideal para que las bacterias naturalmente presentes en nuestra boca crezcan y se desarrollen. Cuando estas se acumulan en dientes y encías, sobre todo en las zonas de unión entre ambos, puede formarse la placa dental.
Con el tiempo, si la placa no se elimina, los minerales de la saliva se depositan en la barrera que crea la placa dental, endureciéndose y formando el sarro. Para que esto suceda solamente es necesario que estos minerales permanezcan entre 24 y 72 horas, tiempo necesario para acerarse y provocar dicha afección.
Los alimentos más comunes que contribuyen a la formación y crecimiento de la placa son aquellos con un alto contenido de carbohidratos o azúcares simples, como sacarosa y almidones, los cuales se encuentran mayormente en refrescos y dulces.

¿Cómo eliminar el sarro?
Tal y como se menciona anteriormente, el sarro se caracteriza por su dureza, que hace imposible que se pueda quitar en casa con el cepillado diario. En consecuencia, para prevenir la aparición de sarro dental es de fundamental importancia mantener una buena higiene dental diaria.
Para eliminar el sarro hay que acudir a un profesional bucodental, como un odontólogo o un higienista dental, los cuales eliminarán esta formación mediante el uso de instrumentos específicamente diseñados para el desbridamiento de las superficies dentales.
Para controlar esta afección de manera eficiente y eliminar por completo la formación de sarro, la persona deberá someterse a varias sesiones, a intervalos frecuentes, de limpieza bucal específica. La frecuencia recomendada para el tratamiento dependerá de las necesidades individuales del paciente.
Existen varias herramientas diseñadas para quitar el sarro de los dientes. Entre estos utensilios encontramos algunos mecánicos, como las herramientas ultrasónicas, y otros manuales, como raspadores, limas o cinceles. Cada uno de ellos se utiliza en áreas específicas de la boca.
Consejos para su prevención
Debido a lo dificultoso de su eliminación y a las complicaciones que puede acarrear, como enfermedades crónicas de las encías, la mejor opción es no permitir que el sarro llegue a formarse en nuestros dientes. A continuación ofrecemos algunos consejos para la prevención del sarro.
1. Cepillados regulares
El cepillado regular de los dientes -concretamente dos veces al día durante al menos dos minutos- es la principal medida para prevenir la formación de placa, que precede al sarro, y la más eficiente.
Es recomendable utilizar un cepillo de cerdas suaves y asegurarse de llegar a las superficies más difíciles de alcanzar, como la parte posterior de los dientes y los molares.
2. Pasta de diente antisarro
La elección de pasta de dientes con flúor y control antisarro también resulta importante a la hora de evitar la formación de éste. El flúor ayuda a reparar el daño del esmalte y el triclosán combate las bacterias de la placa.
3. Seda o hilo dental y enjuagues bucales
Además de un buen cepillado, la utilización de seda o hilo dental es la única manera de eliminar la placa que se forma entre los dientes. De este modo se evita que el sarro se forme en estas zonas de difícil acceso.
Los enjuagues bucales suelen tener propiedades antisépticas; esto significa que ayudan a eliminar las bacterias que causan la placa.
4. Vigilar nuestra dieta
Las bacterias bucales crecen con la ingesta de alimentos azucarados y con almidón. Cuando se encuentran expuestas a estos alimentos, liberan ácidos dañinos para la integridad de los dientes.
Mantener una dieta saludable y limitar la cantidad de alimentos azucarados que ingerimos, junto con una rutina de limpieza dental adecuada, son pasos primordiales en la prevención de la formación de sarro.
5. No fumar
Según los estudios, las personas fumadoras o que consumen otros productos derivados del tabaco tienen más probabilidades de desarrollar sarro dental. Así, este problema es una de las innumerables condiciones médicas asociadas al consumo de tabaco.
Referencias bibliográficas:
- Jepsen, S., Deschner, J., Braun, A., Schwarz, F. & Eberhard, J. (2011). Calculus removal and the prevention of its formation. Periodontology 55 (1): 167–188.
- Jin, Y. & Yip, H. K. (2002). Supragingival calculus: formation and control. Critical Reviews in Oral Biology and Medicine, 13(5): 426–441.